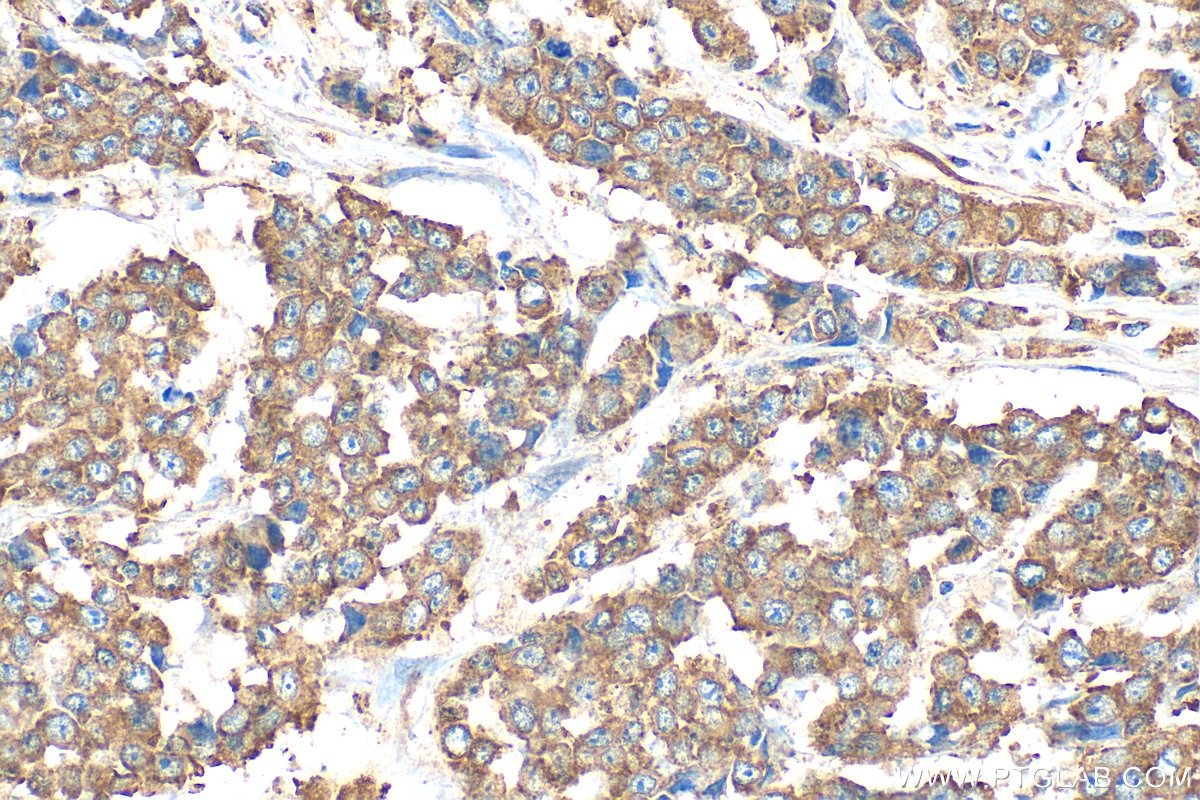
Immunohistochemistry (IHC) staining of human colon cancer tissue using PLA2G12B Polyclonal antibody (25799-1-AP)

Tested Applications
| Positive WB detected in | mouse liver tissue, HepG2 cells, HuH-7 cells, rat liver tissue |
Recommended dilution
| Application | Dilution |
|---|---|
| Western Blot (WB) | WB : 1:500-1:3000 |
| It is recommended that this reagent should be titrated in each testing system to obtain optimal results. | |
| Sample-dependent, Check data in validation data gallery. | |
Product Information
25799-1-AP targets PLA2G12B in WB, ELISA applications and shows reactivity with human, mouse, rat samples.
| Tested Reactivity | human, mouse, rat |
| Host / Isotype | Rabbit / IgG |
| Class | Polyclonal |
| Type | Antibody |
| Immunogen |
CatNo: Ag22877 Product name: Recombinant human PLA2G12B protein Source: e coli.-derived, PET30a Tag: 6*His Domain: 115-195 aa of BC111946 Sequence: LDVCYDTCGANKYRCDAKFRWCLHSICSDLKRSLGFVSKVEAACDSLVDTVFNTVWTLGCRPFMNSQRAACICAEEEKEEL Predict reactive species |
| Full Name | phospholipase A2, group XIIB |
| Calculated Molecular Weight | 195 aa, 22 kDa |
| Observed Molecular Weight | 21-22 kDa |
| GenBank Accession Number | BC111946 |
| Gene Symbol | PLA2G12B |
| Gene ID (NCBI) | 84647 |
| RRID | AB_3085823 |
| Conjugate | Unconjugated |
| Form | Liquid |
| Purification Method | Antigen affinity purification |
| UNIPROT ID | Q9BX93 |
| Storage Buffer | PBS with 0.02% sodium azide and 50% glycerol, pH 7.3. |
| Storage Conditions | Store at -20°C. Stable for one year after shipment. Aliquoting is unnecessary for -20oC storage. 20ul sizes contain 0.1% BSA. |
Background Information
Phospholipase A2 (PLA2) enzymes catalyze hydrolysis of glycolipids to release free fatty acids and lysophospholipids. PLA2G12B is a secreted group XIIB secretory phospholipase A2-like protein belonging to the PLA2 family, but it is catalytically inactive due to an amino acid change in its active site and has altered phospholipid-binding properties (PMID: 14516201). It is located outside the cell membranes and strongly expressed in liver, small intestine and kidney, and recently reports revealed that Pla2g12b gene may be implicated in HDL cholesterol levels and metabolism (PMID: 22912808). The calculated molecular weight of PLA2G12B is 21 kDa.
Protocols
| Product Specific Protocols | |
|---|---|
| IHC protocol for PLA2G12B antibody 25799-1-AP | Download protocol |
| WB protocol for PLA2G12B antibody 25799-1-AP | Download protocol |
| Standard Protocols | |
|---|---|
| Click here to view our Standard Protocols |